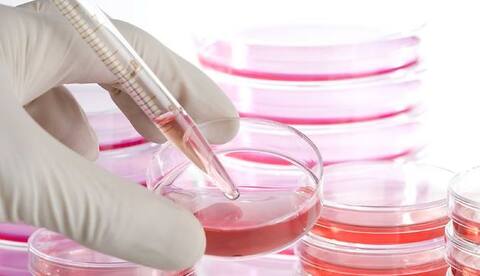

वाशिंगटन: हाल ही में एक भारतीय मूल के वैज्ञानिक और उनकी टीम ने ब्लाइंडनेस के ट्रीटमेंट के लिए स्टेम सेल पर आधारित रेटिनल सेल के निर्माण की दिशा में प्रगति की है.
क्या कहते हैं वैज्ञानिक- अमेरिका के नेशनल आई इंस्टीट्यूट (एनईआई) के वैज्ञानिकों के अनुसार आंख के पिछले हिस्सों में सेल्स की परत प्रकाश की पहचान करने वाले रेटीना के फोटोरिसेप्टर के बने रहने के लिए आवश्यक होता है.
इस खोज से जियोग्रॉफिक एट्रॉफी या ऐज-रिलेटेड मैकुलर डिजिनरेशन (एएमडी) के मरीजों में मूल कोशिका यानी स्टेम सेल पर आधारित रेटिनल पिग्मेंट इपिथेलियम (आरपीई) के ट्रांसप्लांट का मार्ग प्रशस्त हुआ है.
‘सेल रिपोर्ट्स’ जर्नल में प्रकाशित अध्ययन की अगुवाई करने वाले कपिल भारती ने कहा कि हम इस बात को बेहतर तरीके से समझ रहे हैं कि आरपीई सेल्स का निर्माण कैसे होता है और उन्हें कैसे बदला जाता है. ऐसा प्रतीत होता है कि एएमडी में इस तरह के सेल्स सबसे पहले काम करना बंद कर देते हैं.
ये रिसर्च के दावे पर हैं. ABP न्यूज़ इसकी पुष्टि नहीं करता. आप किसी भी सुझाव पर अमल या इलाज शुरू करने से पहले अपने एक्सपर्ट की सलाह जरूर ले लें.